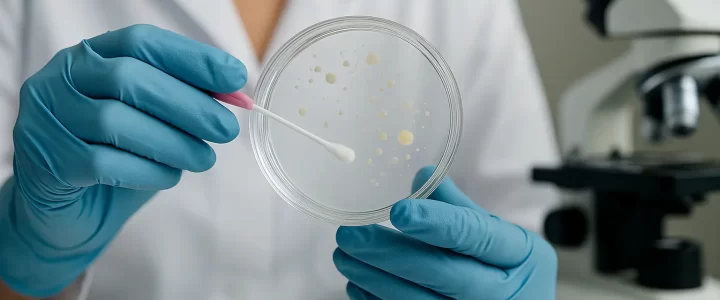
what is emma test

As of 2026, the costs of egg donation treatments vary depending on the country where the procedure is performed, the clinic, the technologies used, and donor selection criteria. Additional procedures such as genetic screening, embryo freezing, or advanced laboratory techniques also play a significant role in determining the total cost.
In general, egg donation prices in 2026 range between €6,000 and €15,000. These figures may vary according to the scope of services offered by the treatment center. However, many clinics provide alternative treatment plans suitable for different budgets.
Key factors influencing pricing include the clinic’s technological infrastructure, laboratory equipment used during treatment, the donor’s medical history, and additional services provided by the clinic. Thanks to continuous advancements in medical infrastructure, costs are expected to remain balanced in 2026, offering more accessible options for couples.
Egg Donation Treatment in 2026
Egg donation is one of the most effective treatment methods for women with diminished ovarian reserve or low chances of pregnancy using their own eggs. In 2026, this method continues to turn the dream of parenthood into reality for thousands of couples worldwide.
During the treatment process, eggs obtained from a healthy donor are fertilized with the recipient’s partner’s sperm to create embryos. These embryos are then transferred to the recipient’s uterus, significantly increasing the chances of pregnancy for couples who cannot conceive naturally.
Advantages of Egg Donation Treatment
Egg donation offers many advantages, especially:
-
High Success Rates: The use of high-quality eggs from young and healthy donors significantly increases the likelihood of pregnancy.
-
Personalized Treatment Planning: Since every couple’s situation is unique, treatment plans are tailored individually, which is a key factor in improving success rates.
-
Use of Advanced Technology: In 2026, many clinics routinely apply advanced techniques such as genetic screening (PGT), intracytoplasmic sperm injection (ICSI), and embryo freezing.
-
Privacy and Security: Donor information is kept confidential throughout the egg donation process, ensuring an ethically and psychologically secure treatment environment.
Popularity of Egg Donation Treatment in 2026
As of 2026, egg donation treatment continues to grow in popularity worldwide. High success rates, reasonable price ranges, and professional services offered by modern clinics make this method increasingly attractive for many couples.
The number of couples traveling from Europe, the Middle East, and North Africa increases every year. One of the main reasons is that technological advancements have significantly improved success rates compared to previous years. Genetic testing, advanced embryo laboratories, and personalized treatment protocols help maximize couples’ chances of having a baby.
Egg Donation in Cyprus (2026)
Cyprus remains one of the leading destinations for egg donation treatment in 2026. With its affordable pricing, high success rates, and experienced medical professionals, Cyprus has become a top choice for couples from both Europe and Turkey.
Egg donation prices in Cyprus range between €5,000 and €8,000, making it a more economical option compared to many European countries. When combined with high success rates, this creates a highly advantageous treatment alternative.
Beyond cost benefits, Cyprus is also preferred for its peaceful environment and comfort offered throughout the treatment process. The Mediterranean climate and relaxing atmosphere help patients experience less stress during treatment.
Advantages of Egg Donation Treatment in Cyprus
-
Affordable Prices: High-quality treatment services are available at significantly lower costs compared to European standards.
-
High Success Rates: Advanced laboratory conditions, genetic analysis capabilities, and experienced specialists contribute to excellent success rates.
-
Internationally Recognized Clinics: IVF clinics in Cyprus achieve high success rates thanks to world-renowned experts and advanced technologies.
-
Relaxing Environment: Cyprus’s natural beauty and calm atmosphere provide strong psychological support during treatment.
-
Easy Accessibility: Direct flights from many cities in Turkey and Europe make travel convenient and hassle-free.
In 2026, egg donation treatment continues to be a safe, effective, and increasingly popular solution worldwide. With advanced laboratory technologies, personalized treatment plans, and cost-effective options, many couples are achieving their dream of parenthood.
Regions like Cyprus, which are well-developed in medical tourism, continue to stand out in this field with their economic advantages and high success rates.

In the field of reproductive health, diagnostic methods are constantly evolving. One of the modern approaches is the Emma Test, which provides valuable insights into women’s uterine health. In this article, we will explain what the Emma Test is, how it is performed, who should consider it, and what the results mean






Hepatitis B is a viral infection that primarily affects the liver, leading to both acute and chronic diseases. Understanding the Hepatitis B risks is crucial for prevention and management. The virus can cause inflammation and permanent liver damage, which may lead to serious complications, including cirrhosis and liver cancer.
In recent years, concern has grown regarding the potential link between fertility treatments and an increased risk of breast cancer. Specifically, the question Does IVF Treatment Increase the Risk of Breast Cancer? has been a pivotal topic of discussion among both patients and medical professionals. Various studies have examined the hormonal changes induced by in vitro fertilization (IVF), which can lead to heightened estrogen levels. Elevated estrogen has been traditionally associated with breast cancer; thus, this connection raises concerns for women undergoing fertility treatments.


